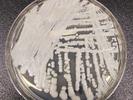

appears in the following:
NBA coach Gregg Popovich criticizes lawmakers over gun control
Monday, April 10, 2023
Popovich, who has coached the Spurs for 27 years, has been outpsoken on issues of gun control, race and LGBTQ+ rights over the years.
A man accused of dealing drugs that led to Michael K. Williams' death pleads guilty
Thursday, April 06, 2023
Irvin Cartagena, 39, allegedly sold fentanyl-laced drugs to an undercover NYPD officer on several occasions. Narcotics found in Williams' apartment were linked back to Cartagena, police say.
A U.K. agency has fined TikTok nearly $16 million for handling of children's data
Wednesday, April 05, 2023
The U.K.'s Information Commissioner's Office said there were up to 1.4 million children under the age of 13 on the app in 2020, despite TikTok's terms of service saying users must be 13 to sign up.
Hit animated film 'Moana' will receive a live-action remake, Disney announced
Tuesday, April 04, 2023
Auli'I Cravalho and Dwayne "The Rock" Johnson, who voiced Moana and Maui, respectively, in the 2016 film, will reprise their roles in the live-action version, Disney said.
Dogecoin price spikes after Elon Musk changes Twitter logo to the Shiba Inu dog
Tuesday, April 04, 2023
Elon Musk is currently facing a $258 billion class-action federal lawsuit accusing him of engaging in a pyramid scheme for voicing his support for Dogecoin in several tweets.
The UConn Huskies beat San Diego State to claim its 5th men's basketball championship
Tuesday, April 04, 2023
The University of Connecticut Huskies defeated the San Diego State Aztecs 76-59 Monday night to claim the school's fifth men's college basketball title.
A father is charged with murder after his son was found dead in an alligator's mouth
Monday, April 03, 2023
Two-year-old Taylen Mosley of St. Petersburg, Florida, was declared missing the same day his mother was found stabbed to death in her apartment, police said.
Authorities are investigating 33 swimmers for allegedly harassing dolphins in Hawaii
Friday, March 31, 2023
The Marine Mammal Protection Act was amended in 2021 to prohibit people from being within 50 feet of spinner dolphins in Hawaii.
These are the states with the highest and lowest tax burdens, a report says
Thursday, March 30, 2023
A new report by WalletHub measured how much people pay in property, income and sales tax in proportion to the amount of money they make.
Melissa Joan Hart says she helped kindergartners escape the Nashville shooting
Thursday, March 30, 2023
Hart, known for her starring role on Sabrina the Teenage Witch, said her children attend school near Nashville's Covenant School.
Another storm is expected to bring more snow and flooding to California
Wednesday, March 29, 2023
Storms have been sweeping across California since last December. Areas with high elevation are forecasted to experience the brunt of this week's extreme weather.
Ralphie the 'demon' French bulldog has been adopted again — hopefully for good
Tuesday, March 28, 2023
Ralphie's new owner Jason trains dogs professionally for the Tennessee state government. Ralphie's former shelter chose him from more than 700 inquiries.
The teams have been set for the NCAA men's Final Four tournament
Monday, March 27, 2023
For three of the teams, it is the first time in school history their men's basketball teams have been to the Final Four.
Jeremy Renner posts a video of him walking again after his snowplow accident
Monday, March 27, 2023
Actor Jeremy Renner was helping a family member retrieve their vehicle from the snow when the accident occurred on New Year's Day.
The Senate Ethics Committee warns Lindsey Graham for fundraising in Senate building
Friday, March 24, 2023
South Carolina Sen. Lindsey Graham was sent a letter Thursday, in which the Senate Ethics Committee found he violated its rule about asking for campaign donations in federal buildings.
A wolverine has been seen outside of its normal range for the first time in 30 years
Friday, March 24, 2023
In Oregon, wolverines are typically located in the Wallowa Mountains in the northeast of the state. But the animal was seen near Portland this week.
California could ban certain food additives due to concerns over health impacts
Thursday, March 23, 2023
The bill would ban several common ingredients used in processed foods, such as Red Dye No. 3, which has been linked to cancer in animal studies.
8 dolphins died after washing ashore in New Jersey
Wednesday, March 22, 2023
Two dolphins were discovered on the shore in Sandy Hook Bay in New Jersey last week. By Tuesday, rescuers had discovered eight stranded dolphins in total.
The potentially deadly Candida auris fungus is spreading quickly in the U.S.
Tuesday, March 21, 2023
Cases of the fungus that did not respond to antifungal medicine tripled in 2021. It can be deadly, but does not seem to have adverse effects on healthy people.
Millions of dead fish have been found in an Australian river due to low oxygen levels
Monday, March 20, 2023
Millions of dead fish have been found dead in an Australian river due to dangerously low oxygen levels in the water caused by receding flood waters, government officials said.